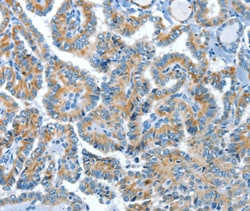
Invitrogen COG1 Polyclonal Antibody 100 &mu;L; Unconjugated:Antibodies,

missing translation for 'onlineSavingsMsg'
Learn More
Learn More
Invitrogen™ COG1 Polyclonal Antibody


Rabbit Polyclonal Antibody
Brand: Invitrogen™ PA550640
This item is not returnable.
View return policy
Description
The antibody detects endogenous levels of total COG1 protein.
The protein encoded by this gene is one of eight proteins which form a Golgi-localized complex required for normal Golgi morphology and function. It is thought that this protein is required for steps in the normal medial and trans Golgi-associated processing of glycoconjugates and plays a role in the organization of the Golgi-localized complex.
Specifications
| COG1 | |
| Polyclonal | |
| Unconjugated | |
| COG1 | |
| 6030445I15; CDG2G; COG complex subunit 1; Cog1; Component of oligomeric Golgi complex 1; conserved oligomeric Golgi complex protein 1; conserved oligomeric Golgi complex subunit 1; DKFZp762L1710; KIAA1381; Ldlb; low density lipoprotein B; low density lipoprotein receptor defect B complementing; low density lipoprotein receptor defect B-complementing protein; mKIAA1381 | |
| Rabbit | |
| Antigen affinity chromatography | |
| RUO | |
| 9382 | |
| -20°C | |
| Liquid |
| Immunohistochemistry (Paraffin) | |
| 2.7 mg/mL | |
| PBS with 40% glycerol and 0.05% sodium azide; pH 7.4 | |
| Q8WTW3 | |
| COG1 | |
| Synthetic peptide corresponding to a region derived from internal residues of human component of oligomeric golgi complex 1. | |
| 100 μL | |
| Primary | |
| Human | |
| Antibody | |
| IgG |
Product Content Correction
Your input is important to us. Please complete this form to provide feedback related to the content on this product.
Product Title
Spot an opportunity for improvement?Share a Content Correction